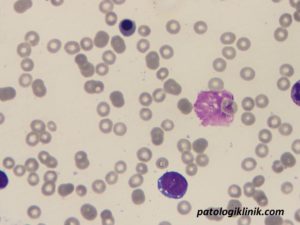
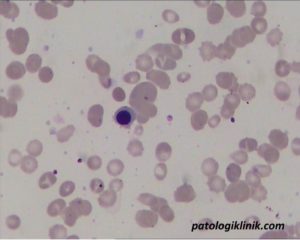

Normoblastemia pada Neonatus dan Bayi
Normoblas adalah eritrosit berinti yang kurang dapat berubah bentuk jika dibandingkan dengan eritrosit matur dan jarang masuk ke sirkulasi. Adanya normoblas menunjukkan adanya kerusakan sawar sumsum tulang atau teraktivasinya hematopoiesis ekstrameduler.

Mengidentifikasi normoblas di darah tepi sangat penting karena selain bisa menjadi tanda yang buruk bagi pasien, juga menimbulkan permasalahan tersendiri dari segi laboratorium. Permasalahan laboratorium akibat normoblastemia dapat dibaca pada artikel berikut:
Normoblas di Darah Tepi dan Permasalahan Laboratoriumnya
Normoblastemia fisiologis pada neonatus
Normoblas sejumlah 0-10 per 100 leukosit dapat ditemukan pada neonatus normal sampai usia 5 hari, dengan jumlah di atas 10-20 per 100 leukosit dianggap meningkat. Nilai normal normoblas pada beberapa jam pertama kelahiran sekitar 500/mm3, dengan jumlah 1.000/mm3 dianggap meningkat. Pada usia 12 jam, jumlah normoblas turun 50% dan setelah 48 jam hanya ditemukan 20-30 normoblas. Normoblas pada neonatus aterm tidak ditemukan lagi setelah usia 3 atau 4 hari. Pada neonatus yang prematur dapat ditemukan 10.000 normoblas/mm3 dan dapat persisten selama satu minggu.

Normoblastemia patologis
Berbagai penyebab normoblastemia patologis pada neonatus dan bayi dapat dilihat pada tabel di atas, di antaranya oleh karena hipoksia, anemia, dan penyebab lainnya. Sekitar 8-15 normoblas per 100 leukosit dapat ditemukan pada kondisi hipoksia kronis, sedangkan pada kondisi hipoksia akut dan hipoksia akibat kelainan jantung kongenital jumlah normoblas bisa ditemukan lebih dari 2.000/mm3. Hal ini disebabkan oleh peningkatan produksi eritroipoietin akibat hipoksia jaringan yang memicu stimulasi eritropoiesis.
Pada semua jenis anemia berat, yaitu hemolitik, defisiensi nutrisi, atau perdarahan juga dapat menyebabkan hipoksia jaringan, yang memicu produksi eritropoietin oleh ginjal sehingga meningkatkan aktivitas eritropoiesis di sumsum tulang. Anemia dengan normoblastemia harus meningkatkan kecurigaan terjadinya perdarahan pada neonatus, dimana jumlah normoblas bisa mencapai 2.000/mm3 dalam waktu 2 jam setelah perdarahan.
Ditemukannya normoblas pada darah tepi neonatus dan bayi memang tidak langsung menunjukkan diagnosis pasien, tapi dapat memberikan tanda adanya penyakit serius yang mendasari. Normoblas bisa langsung dideteksi oleh berbagai teknologi hematologi terbaru berikut jumlahnya, tapi tetap harus dikonfirmasi secara manual, karena kadangkala pada kasus tertentu jumlah penghitungannya yang kurang akurat.
Semoga bermanfaat.
Sumber:
Angel SE, Geothe J. Normoblastemia in Neonates and Infants. IMA Kerala Medical Journal. 2016 Mar 30;9(1):32-35.